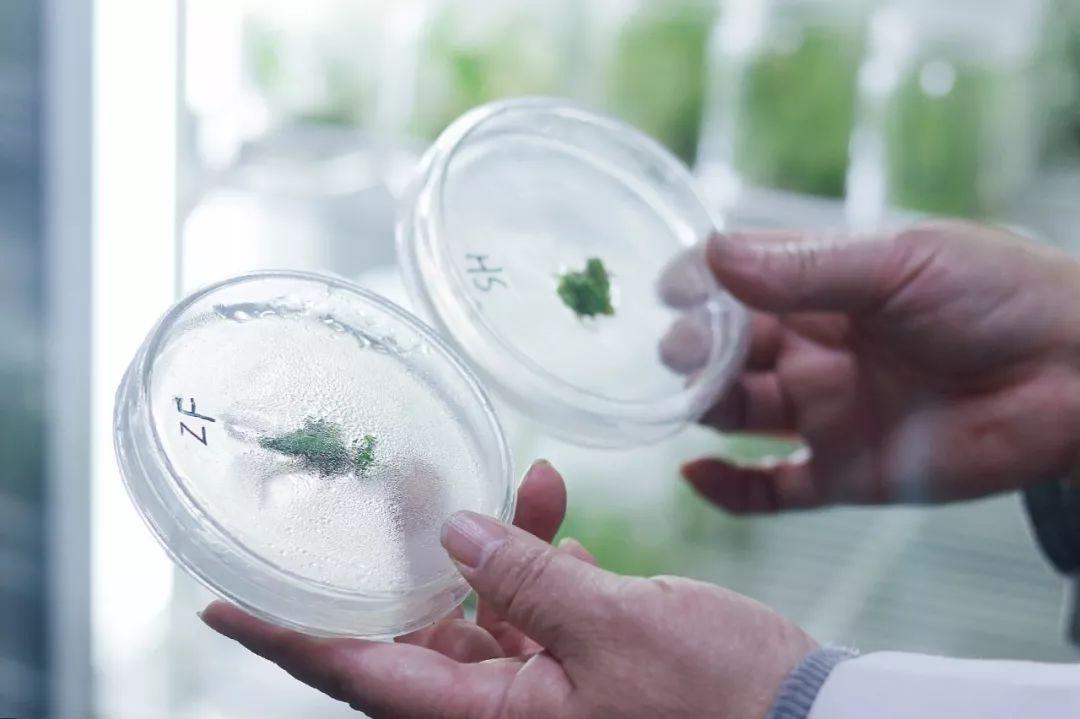

前沿拓展:種植牙多少天才能成活體
在我國的農(nóng)村,有句俗語“千年草籽,萬年魚籽”。意思是,有些植物的種子在合適的地方埋藏1000年,也不會損壞。當(dāng)這些種子遇到適量的水,空氣,陽光和土壤,它們就會破土而出,生根發(fā)芽。
而魚籽則是在干燥的地方埋藏了10000年,也是有生命的。當(dāng)它們遇到水源在適合生活的環(huán)境中,就會孵化出小魚,靈活地游動。

萬魚籽年
魚籽是否真的能在萬年以后還能孵化成小魚我們很難去考證。但是關(guān)于草籽,在科學(xué)家們不懈的努力下,超過1000年種子在新的科技下我們也能一睹其芳容。古老的種子距現(xiàn)在已經(jīng)有3萬余年了。它就是柳葉蠅子草的種子。我們一起來了解一下究竟是怎么一回事吧。
古老的種子被復(fù)活
相信在四川地區(qū)的朋友對于柳葉蠅子草并不陌生。這種石竹科蠅子草屬的植物大多生活在海拔2100米到2300米的林間巖石上。

柳葉蠅子草
俄羅斯的科學(xué)家稱,他們成功地復(fù)活了3萬年的古柳葉蠅子草的種子。這應(yīng)該算是目前復(fù)活的古老的種子了。
他們在西伯利亞的東北部,科累馬河附近的凍土層中發(fā)現(xiàn)了這些種子。研究學(xué)者推測發(fā)現(xiàn)種子的地方應(yīng)該是數(shù)萬年前松鼠存儲食物的洞穴。這個洞穴在地下38米深的地方,除了柳葉蠅子草以外,還有別的一些植物的種子和果實。

松鼠洞穴
根據(jù)放射性碳年代測定法顯示,這些種子和果實的時間應(yīng)該是在2.8萬年到3.2萬年期間。要知道,那個時候還是猛犸象和穴居人的年代啊。
剛開始的時候,科學(xué)家直接將種子進(jìn)行了播種,發(fā)現(xiàn)種子很難自我的突破外殼然后發(fā)芽生長。于是他們提取了有活性的,未成熟果實中的胎座中的組織,利用植物的克隆技術(shù),成功地復(fù)活了3萬年前的柳葉蠅子草。
植物克隆技術(shù)
一共獲取了36株活體植物。在復(fù)活的這些柳葉蠅子草中,科學(xué)家又有了新的發(fā)現(xiàn)。古柳葉蠅子草和我們今天看到的柳葉蠅子草還是有些輕微的差別的。
現(xiàn)代柳葉蠅子草的花瓣更加的寬,花裂也更加的深。而且現(xiàn)代的柳葉蠅子草種子的發(fā)芽率只有86%-90%,就是說它們的種子不是百分百會發(fā)芽的。但是古柳葉蠅子草的種子發(fā)芽率能達(dá)到。

柳葉蠅子草
可見,3萬年的時間,柳葉蠅子草也隨著氣候自然的改變發(fā)生了一定的變異和進(jìn)化。
植物克隆技術(shù)復(fù)活種子的條件
上面有提到,俄羅斯的科學(xué)家是利用植物克隆技術(shù)完成對古柳葉蠅子草的成功“復(fù)活”。那么什么是植物克隆技術(shù)呢?植物克隆技術(shù)指的是將快速成苗技術(shù)與多代循環(huán)技術(shù)相結(jié)合大批量的種植植物。

植物克隆原理圖
快速成苗技術(shù)一般是指在計算機(jī)的智能控制下,利用營養(yǎng)液和激素的方式,使植物離開土壤之后培育。多代循環(huán)技術(shù)的意思是復(fù)制成功培訓(xùn)的植物小苗。兩者相結(jié)合就能使得植物在人工的干預(yù)下數(shù)量成幾何倍的增長。
所以這次俄羅斯科學(xué)家復(fù)活的柳葉蠅子草上必須滿足兩個重要的條件。第一個是在層凍土發(fā)現(xiàn)的種子種還具有活性的胎座組織。就是因為特殊的環(huán)境,這些種子中還具有活性細(xì)胞。簡單地說就是有生命跡象。

西伯利亞的層凍土
第二是科學(xué)家必須使用植物克隆的技術(shù),不能讓它們直接在土壤里“復(fù)活”。將植物的組織培養(yǎng)液用于分離好的植物細(xì)胞中,在無菌操作的環(huán)境下,以人工干涉的方式進(jìn)行培育。
類似于這樣的植物克隆技術(shù)大的好處在于無論種子的年份如何,只要它們中有活性的胎座組織,就能夠通過這樣的方式“復(fù)活”。

植物的細(xì)胞結(jié)構(gòu)圖
也證明了植物中的每一個活性細(xì)胞都記錄著植物的全部遺傳信息。在一定的條件下,就可以發(fā)育成一顆完整的植物,并且在一定的范圍內(nèi),人們可以根據(jù)自己的意愿改良植物的某些屬性。
復(fù)活古植物行動
古蓮子
無獨有偶,在我國,中科院植物研究所也“復(fù)活”了圓明園中的古蓮花。在圓明園考古的時候在鏡香池內(nèi)發(fā)現(xiàn)了11顆古蓮子。經(jīng)過中科院專家的細(xì)心培育,其中有6顆古蓮子順利地發(fā)芽,并在2018年的時候在實驗盆中結(jié)出了蓮藕。

古蓮花
由于古蓮子埋藏的時間太長了,所以專家用了很長的時間才喚醒它們。它們的發(fā)芽時間也比普通的蓮子要久一些。在開花與結(jié)藕等方面與現(xiàn)代蓮花相比也是相對較差的。
古椰棗樹
在成功“復(fù)活”柳葉蠅子草之前,人類復(fù)活的古老植物種子是2000多年前的椰棗樹種子。以色列的科學(xué)家在死海附近的馬薩達(dá)古城的遺跡中發(fā)現(xiàn)的這批種子。

古椰棗樹
他們將其帶回后,把種子浸泡在溫水中,之后撒上從海帶中提取的特殊物質(zhì)作為肥料,后再將其移植在花盆里。在他們的精心照顧下,幾周后,小樹芽破土而出。
小結(jié)
在大自然中,所有的生物都遵循著適者生存,優(yōu)勝劣汰的生存法則。從這些古生物種子培育出來的植物和現(xiàn)代同種植物的對比中就能發(fā)現(xiàn),它們也在不斷地進(jìn)化來適應(yīng)環(huán)境的變化。

人類與自然和諧共處
各位看官,你們還聽過什么古生物在現(xiàn)在的技術(shù)下“復(fù)活”的故事嗎?歡迎與我們分享哦。
拓展知識:種植牙多少天才能成活體
您好!要根據(jù)你牙齒的具體情況,人工種植牙的整體調(diào)節(jié)程序大約需要3—6個月時間,分為以下三個階段。(1)術(shù)前檢查、制定種植調(diào)節(jié)方案:對缺牙部位及整個口腔狀況進(jìn)行系統(tǒng)性檢查,拍攝口腔X線片,并做相應(yīng)處理。根據(jù)患者具體情況制定種植調(diào)節(jié)方案。預(yù)約種植手術(shù)時間。
(2)種植手術(shù)階段:在局部麻醉下,通過手術(shù)將人工牙根,即種植體植入牙槽骨內(nèi),通常植入一枚種植體的時間約為10-30分鐘,術(shù)中不會有疼痛感,術(shù)后反應(yīng)也較小。若缺牙部位骨量不足,需要植入一些人工骨粉材料進(jìn)行補(bǔ)充??傮w來說,種植手術(shù)是一種創(chuàng)傷較小的口腔門診手術(shù)。種植手術(shù)后,患者無需住院,當(dāng)天吃軟食,24個小時內(nèi)不能刷牙、漱口,通常口服消炎藥3-5天。種上人工牙根之后需要2-6個月的時間使人工牙根與牙槽骨結(jié)合在一起,這段時間患者可以戴臨時假牙。
(3)修復(fù)牙冠:種植術(shù)后2-6個月,待人工牙根與牙槽骨完全結(jié)合在一起以后,開始進(jìn)行種植體的牙冠修復(fù)過程,這一過程大約需要一個月的時間。通常,牙冠為金屬烤瓷冠,其質(zhì)地優(yōu)良、色澤逼真,舒適美觀,恢復(fù)功能滿意,經(jīng)久耐用。戴上牙冠完成終修復(fù)后,需要每隔半年至一年復(fù)查一次,定期維護(hù)利于種植牙的長期使用。
希望能夠幫到您?。海?
【北京三級口腔醫(yī)院】種植牙的手術(shù)時間一般整體調(diào)節(jié)程序大約3-6個月點擊申領(lǐng)種牙補(bǔ)貼
。分為以下三個階段:1、術(shù)前檢查,制定種植調(diào)節(jié)方案階段。對缺牙部位及整個口腔狀況進(jìn)行系統(tǒng)性檢查,拍攝口腔X線片,有條件的時候拍攝CBCT,根據(jù)情況進(jìn)行調(diào)節(jié)計劃的制定。2、種植手術(shù)階段。在局部麻醉下將人工種植體植入患者的牙槽骨內(nèi),通常這個手術(shù)時間為半個小時到一個半小時之間。如缺牙部位骨量不足,需要人工骨粉材料進(jìn)行補(bǔ)充,如條件不好還需要進(jìn)行相應(yīng)的外科手術(shù)。種植手術(shù)后一般24小時之內(nèi)不能刷牙、漱口,可以口服一些消炎止疼藥。這段時間可以戴臨時假牙,也可以不戴。3、修復(fù)牙冠階段。種植術(shù)后2-6個月,需要等待人工牙根與牙槽骨完全結(jié)合在一起以后,才開始進(jìn)行種植體上部的牙冠修復(fù)過程,這個過程大約需要一個月的時間。所以,整個種植過程需要的時間是3-6個月,種植完成以后還需要每隔半年到一年進(jìn)行一次復(fù)查,定期對于種植體進(jìn)行維護(hù)。
想了解更多關(guān)于種植牙齒的相關(guān)信息,可以去中諾口腔醫(yī)院進(jìn)行了解。該機(jī)構(gòu)采用人性化、標(biāo)準(zhǔn)化管理,重視學(xué)術(shù)交往與交流,定期與國內(nèi)多家知名三甲口腔醫(yī)院進(jìn)行經(jīng)驗交流及學(xué)術(shù)研討,以積極向上的學(xué)習(xí)態(tài)度,吸取先進(jìn)科技手段,專注于口腔事業(yè),為廣大的客戶提供優(yōu)質(zhì)的牙齒種植方案。
種植牙用的種植系統(tǒng)一般分為兩期:種植系統(tǒng)包括一期手術(shù)種植體和二期手術(shù)種植體,一期性種植系統(tǒng)基臺與種植體為一個直接相連的整體,基臺直接伸入口內(nèi);二次性種植基臺與種植體不是一個預(yù)成的整體,而是待種植體與其周圍骨床直接愈合后,再切開粘骨膜行基臺連接術(shù)。
種植牙整個過程需要時間:兩者修復(fù)時間有一定差別。一次性柱狀種植較簡單省事,通過一次手術(shù)便可完成,拆線后即可用暫時修復(fù)體修復(fù),種植體穩(wěn)定3個月后可取模,再過幾周可完成恒久修復(fù)。
好一次手術(shù)完成后不要修復(fù),等8周后種植體基本穩(wěn)定可做一暫時修復(fù)體,等6個月之后再做修復(fù)體。
第一期手術(shù)植入種植體后3~6個月,上頜5~6個月,下頜3~4個月,待種植體骨界面愈合后,種植體已可勝任支持修復(fù)體的功能,這時行二期手術(shù),接出基臺。
再過2周,可以開始修復(fù)調(diào)節(jié),并定期復(fù)查。這種種植方法因其果好,被廣泛應(yīng)用。愈合過程不管哪類種植體都要3~6個月,然后開始修復(fù),6~18個月為骨改建過程,以后進(jìn)入穩(wěn)定狀態(tài),但病人要定期復(fù)查,以有問題及時處理。
種植牙整個過程所需時間現(xiàn)在大家已經(jīng)有所了解了,有的患者可能感覺修復(fù)時間有點長,不過沒有辦法,為了擁有好牙齒,只能慢慢來,所以希望想做種植牙的患者能做好思想準(zhǔn)備工作,盡量配合醫(yī)生,在各方面要謹(jǐn)遵醫(yī)囑,才能有好的果。
每個人都希望擁有一口潔白整齊的牙齒,可是生活中有一部分人由于年齡的增長使得牙齒出現(xiàn)了很多的問題,比如說牙齒掉落是很多愛美者都面臨的困擾。關(guān)于這樣的現(xiàn)象,如今好的解決方法就是選擇牙齒種植手術(shù)。種植牙手術(shù)全過程要多長時間須要看種植體與骨組織的愈合情況來定,短3-4個月,時間長的須要8-12個月,手術(shù)時間大概選用20分鐘-120分鐘。
種植牙齒需要多長時間
1、大家需要注意的是,如果你是想通過種植牙方法來修復(fù)牙齒缺損,那么在做種植牙之前就必須接受牙科醫(yī)生詳盡而系統(tǒng)的檢查,這一過程是重要的,它的目地以是確認(rèn)您是否適合種植牙方法修復(fù)。在這一過程中從安排手術(shù)、植入種植體、后到術(shù)后觀察期約需一周時間。
2、種植體需要三個月以上的時間才能在骨內(nèi)達(dá)到愈合。
3、取模型,專業(yè)人士會根據(jù)愛美者的口腔情況制作種植牙上部的牙冠,這一過程大約需要1周。期間若需要植骨、二期牙齦成型術(shù)、調(diào)節(jié)其它問題等可能需要的時間多一些。
建議愛美者到一些正規(guī)的整形醫(yī)院找一些經(jīng)驗相對豐富的整形醫(yī)生進(jìn)行牙齒種植,這樣才能更好的保障術(shù)后的果以及種植牙齒的性。并且手術(shù)前一定要對自己的身體做的檢查,身體沒有任何的異常時,再進(jìn)行手術(shù)。
還有其他疑惑?想了解更多?可以點擊 【在線咨詢】
